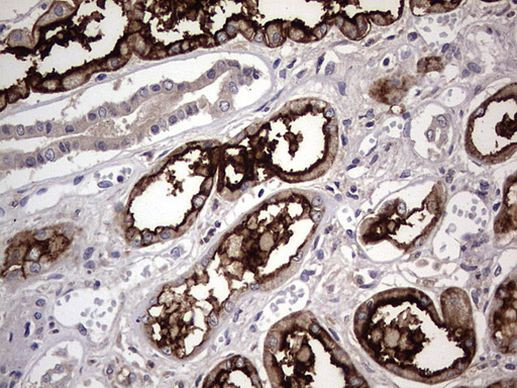
ACE2 Antibody in Immunohistochemistry (Paraffin) (IHC (P))

Search
OriGene
ACE2 Monoclonal Antibody (OTI4C5), TrueMAB™
{{$productOrderCtrl.translations['antibody.pdp.commerceCard.promotion.promotions']}}
{{$productOrderCtrl.translations['antibody.pdp.commerceCard.promotion.viewpromo']}}
{{$productOrderCtrl.translations['antibody.pdp.commerceCard.promotion.promocode']}}: {{promo.promoCode}} {{promo.promoTitle}} {{promo.promoDescription}}. {{$productOrderCtrl.translations['antibody.pdp.commerceCard.promotion.learnmore']}}
产品信息
CF803844
种属反应
宿主/亚型
分类
类型
克隆号
抗原
偶联物
形式
浓度
纯化类型
保存液
内含物
保存条件
运输条件
产品详细信息
For reconstitution, we recommend adding 100 µL distilled water to a final antibody concentration of about 1 mg/mL. To use this carrier-free antibody for conjugation experiments, we strongly recommend performing another round of desalting. (Zeba Spin Desalting Columns, 7KMWCO, 0.5 mL, Product # 89882)
靶标信息
Angiotensin-converting enzyme 2 (ACE2) plays a central role in vascular, renal, and myocardial physiology. In contrast to its homolog ACE, ACE2 expression is restricted to heart, kidney, and testis. Recently. ACE2 has also been shown to be a functional receptor of the SARS coronavirus. The normal function of ACE2 is to convert the inactive vasoconstrictor angiotensin I (AngI) to Ang1-9 and the active form AngII to Ang1-7, unlike ACE, which converts AngI to AngII. While the role of these vasoactive peptides is not well understood, lack of ACE2 expression in ace2-/ace2- mice leads to severely reduced cardiac contractility, indicating its importance in regulating heart function.
仅用于科研。不用于诊断过程。未经明确授权不得转售。
篇参考文献 (0)
生物信息学
蛋白别名: ACE 2; ACE-related carboxypeptidase; ACEH; angiotensin I converting enzyme (peptidyl-dipeptidase A) 2; Angiotensin-converting enzyme 2; Angiotensin-converting enzyme homolog; Angiotensin-converting enzyme-related carboxypeptidase; Metalloprotease MPROT15; peptidyl-dipeptidase A
基因别名: ACE2; ACEH; UNQ868/PRO1885
UniProt ID: (Human) Q9BYF1
Entrez Gene ID: (Human) 59272